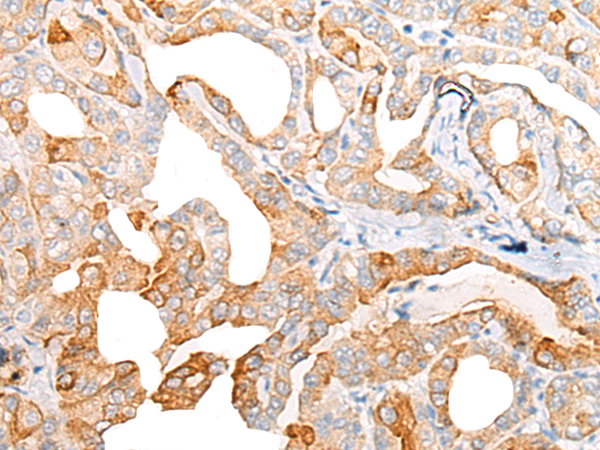

|
Background: |
Key component of the cytosolic iron-sulfur protein assembly (CIA) complex, a multiprotein complex that mediates the incorporation of iron-sulfur cluster into extramitochondrial Fe/S proteins. Seems to specifically modulate the transactivation activity of WT1. As part of the mitotic spindle-associated MMXD complex it may play a role in chromosome segregation. |
|
Applications: |
ELISA, IHC |
|
Name of antibody: |
CIAO1 |
|
Immunogen: |
Fusion protein of human CIAO1 |
|
Full name: |
cytosolic iron-sulfur assembly component 1 |
|
Synonyms: |
CIA1; WDR39 |
|
SwissProt: |
O76071 |
|
ELISA Recommended dilution: |
5000-10000 |
|
IHC positive control: |
Human thyroid cancer |
|
IHC Recommend dilution: |
20-100 |
購物車
購物車 幫助
幫助
 021-54845833/15800441009
021-54845833/15800441009
